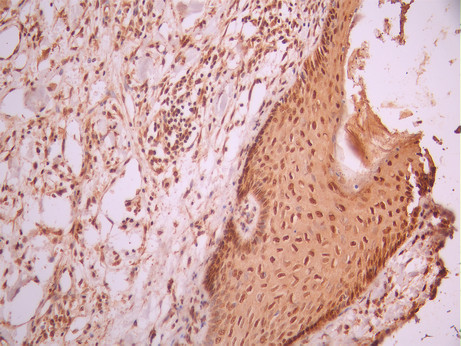
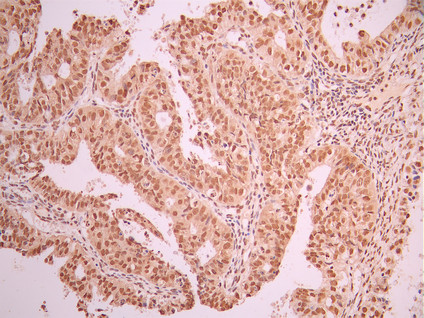

ERCC2 Recombinant Monoclonal Antibody
-
中文名稱:ERCC2 Recombinant Monoclonal Antibody
-
貨號:CSB-RA250899A0HU
-
規格:¥1320
-
圖片:
-
Western Blot
Positive WB detected in: Hela whole cell lysate(30μg), K562 whole cell lysate(30μg), COLO205 whole cell lysate(30μg), U251 whole cell lysate(30μg), THP-1 whole cell lysate(30μg)
All lanes: XPD binding protein 1 antibody at 1:1000
Secondary
Goat polyclonal to rabbit IgG at 1/40000 dilution
Predicted band size: 87 kDa
Observed band size: 87 kDa
Exposure time:2min -
IHC image of CSB-RA250899A0HU diluted at 1:100 and staining in paraffin-embedded human skin tissue performed on a Leica BondTM system. After dewaxing and hydration, antigen retrieval was mediated by high pressure in a citrate buffer (pH 6.0). Section was blocked with 10% normal goat serum 30min at RT. Then primary antibody (1% BSA) was incubated at 4°C overnight. The primary is detected by a Goat anti-rabbit polymer IgG labeled by HRP and visualized using 0.05% DAB.
-
IHC image of CSB-RA250899A0HU diluted at 1:100 and staining in paraffin-embedded human ovarian cancer performed on a Leica BondTM system. After dewaxing and hydration, antigen retrieval was mediated by high pressure in a citrate buffer (pH 6.0). Section was blocked with 10% normal goat serum 30min at RT. Then primary antibody (1% BSA) was incubated at 4°C overnight. The primary is detected by a Goat anti-rabbit polymer IgG labeled by HRP and visualized using 0.05% DAB.
-
Immunofluorescence staining of HeLa cell with CSB-RA250899A0HU at 1:50 , counter-stained with DAPI. The cells were fixed in 4% formaldehyde, permeabilized using 0.2% Triton X-100 and blocked in 10% normal Goat Serum. The cells were then incubated with the antibody overnight at 4°C. The secondary antibody was Alexa Fluor 488-congugated AffiniPure Goat Anti-Rabbit IgG(H+L).
-
-
其他:
產品詳情
-
Uniprot No.:
-
基因名:
-
別名:TFIIH 80 kDa subunit antibody; Basic transcription factor 2 80 kDa subunit antibody; BTF2 p80 antibody; COFS 2 antibody; COFS2 antibody; CXPD antibody; DNA excision repair protein ERCC 2 antibody; DNA excision repair protein ERCC-2 antibody; DNA repair protein complementing XP D cells antibody; DNA repair protein complementing XP-D cells antibody; EM9 antibody; ERCC 2 antibody; ERCC2 antibody; ERCC2_HUMAN antibody; Excision repair 2 antibody; Excision repair cross complementing rodent repair deficiency complementation antibody; Excision repair cross complementing rodent repair deficiency; complementation group 2 antibody; MAG antibody; MGC102762 antibody; MGC126218 antibody; MGC126219 antibody; OTTHUMP00000045860 antibody; OTTHUMP00000045861 antibody; OTTHUMP00000045862 antibody; OTTHUMP00000045863 antibody; TFIIH 80 kDa subunit antibody; TFIIH basal transcription factor complex 80 kDa subunit antibody; TFIIH Basal Transcription Factor Complex Helicase Subunit antibody; TFIIH basal transcription factor complex helicase XPD subunit antibody; TFIIH basal transcription factor complex p80 subunit antibody; TFIIH p80 antibody; TTD antibody; Xeroderma pigmentosum complementary group D antibody; Xeroderma pigmentosum group D complementing protein antibody; Xeroderma pigmentosum group D-complementing protein antibody; XPD antibody; XPDC antibody
-
反應種屬:Human
-
免疫原:A synthesized peptide from human ERCC2 protein
-
免疫原種屬:Homo sapiens (Human)
-
標記方式:Non-conjugated
-
克隆類型:Monoclonal
-
抗體亞型:Rabbit IgG
-
純化方式:Affinity-chromatography
-
克隆號:17G12
-
濃度:It differs from different batches. Please contact us to confirm it.
-
保存緩沖液:Rabbit IgG in 10mM phosphate buffered saline , pH 7.4, 150mM sodium chloride, 0.05% BSA, 0.02% sodium azide and 50% glycerol.
-
產品提供形式:Liquid
-
應用范圍:ELISA, WB, IHC, IF
-
推薦稀釋比:
Application Recommended Dilution WB 1:500-1:5000 IHC 1:50-1:200 IF 1:50-1:200 -
Protocols:
-
儲存條件:Upon receipt, store at -20°C or -80°C. Avoid repeated freeze.
-
貨期:Basically, we can dispatch the products out in 1-3 working days after receiving your orders. Delivery time maybe differs from different purchasing way or location, please kindly consult your local distributors for specific delivery time.
-
用途:For Research Use Only. Not for use in diagnostic or therapeutic procedures.
相關產品
靶點詳情
-
功能:ATP-dependent 5'-3' DNA helicase, component of the general transcription and DNA repair factor IIH (TFIIH) core complex, which is involved in general and transcription-coupled nucleotide excision repair (NER) of damaged DNA and, when complexed to CAK, in RNA transcription by RNA polymerase II. In NER, TFIIH acts by opening DNA around the lesion to allow the excision of the damaged oligonucleotide and its replacement by a new DNA fragment. The ATP-dependent helicase activity of XPD/ERCC2 is required for DNA opening. In transcription, TFIIH has an essential role in transcription initiation. When the pre-initiation complex (PIC) has been established, TFIIH is required for promoter opening and promoter escape. Phosphorylation of the C-terminal tail (CTD) of the largest subunit of RNA polymerase II by the kinase module CAK controls the initiation of transcription. XPD/ERCC2 acts by forming a bridge between CAK and the core-TFIIH complex. Involved in the regulation of vitamin-D receptor activity. As part of the mitotic spindle-associated MMXD complex it plays a role in chromosome segregation. Might have a role in aging process and could play a causative role in the generation of skin cancers.
-
基因功能參考文獻:
- Polymorphic variants of XRCC1 Arg399Gln and XPD Lys751Gln are not associated with the risk of gastric cancer in the Kashmiri population. PMID: 30225185
- A significant association was discovered between the rs1799793 A allele and increased Diffuse Large B-Cell Lymphoma risk (P=0.031, OR=1.928, 95% CI=1.052-3.534). The C allele of rs13181 was obviously associated with elevated Diffuse Large B-Cell Lymphoma susceptibility (P=0.047, OR=1.820, 95% CI=1.002-3.305). PMID: 30279407
- Results identified a significant relationship between SNP rs13181 of ERCC2 and an increased risk of endometrial cancer development. PMID: 30194171
- ERCC2 polymorphism is associated with breast cancer susceptibility. PMID: 29544444
- These results provide new evidence to reveal the role of XPD in Cutaneous squamous cell carcinoma A431 cells. PMID: 29362353
- studied SNPs in XRCC1 and XPD have no association with the incidence of age related cataract in the analyzed group of subjects. PMID: 28560653
- results indicate that the ERCC2 Lys751Gln polymorphism might be important in stimulating the development of pancreatic cancer, especially for Asians. PMID: 28223548
- our results suggested that ERCC2 Asp312Asn polymorphism is associated with increased cancer risk. A significantly increased cancer risk was observed in Asian populations, but not in Caucasian populations. PMID: 28489582
- hospital workers as a category are at risk for genotoxic damage caused by chronic exposure to xenobiotics. The higher levels of cytogenetic damage observed among GSTT1 null, XPD 751 and XPC 939 CC homozygote subjects confirm the importance of the genetic polymorphisms analysis associated to genotoxicological studies. PMID: 28434254
- XPD Lys/Lys might play a facilitating role in the development of OCD. PMID: 29264886
- XPG rs2296147T>C polymorphism is associated with response to therapy in cancer. PMID: 27588464
- We found that the T allele of ERCC2-rs1799793 and the A allele of ERCC3-rs4150441, interaction between rs1799793 and rs4150441, and haplotype containing the rs1799793T and rs11615-T alleles were all associated with increased osteosarcoma risk PMID: 28474168
- meta-analysis indicates that XRCC2 rs3218536 and ERCC2 rs13181 polymorphisms may not be associated with the risk of ovarian cancer PMID: 27863412
- Results show that the response to treatment depended of the variability in genes engaged in drugs' transport ABCC2 c.-24C>T and ABCB1 p.Ser893Ala/Thr and in DNA repair machinery ERCC2 p.Lys751Gln. PMID: 27527855
- Results indicate that ERCC excision repair 2 (ERCC2) is a potential target of miR-770-5p. PMID: 27449101
- The allele combination of CGC from hOGG1, ITGA2 and XPD polymorphisms was significantly associated with increased odds of nasopharyngeal carcinoma. PMID: 29121049
- CHD1 facilitates substrate handover from XPC to the downstream TFIIH (transcription factor IIH). PMID: 29018037
- our study provided preliminary evidence that the ERCC2 rs50872 T allele was associated with a favorable survival while the XRCC1 rs25487 A allele was associated with a worse survival outcome for advanced NSCLC patients. PMID: 27465648
- Genetic polymorphism in ERCC2 gene is associated with response to chemotherapy in osteosarcoma. PMID: 28388903
- XPD 312 single nucleotide polymorphism is associated with Non-Small-Cell Lung Cancer. PMID: 27908619
- At 24 months of follow-up, patients with xeroderma pigmentosum group D protein (XPD) c.934AA genotype presented lower progression-free survival and overall survival in Kaplan-Meier estimates. PMID: 26918827
- the association of six non-synonymous coding variants from XRCC1, XRCC3 and XPD genes with hepatocellular carcinoma risk, was assessed. PMID: 27306318
- characterized by a broad spectrum of base changes. In addition, we note an association between the activity of this signature and smoking that is independent of ERCC2 mutation status, providing genomic evidence of tobacco-related mutagenesis in urothelial cancer PMID: 27111033
- Hypermethylation within the promoter region of the ERCC2 gene is associated with gastric cancer. PMID: 27607585
- significant interactions between ERCC2 (Lys751Gln) and ERCC3 (7122 A>G) genotypes polymorphism and cadmium exposure in association with nasal polyposis disease PMID: 27838878
- ERCC2 mutation is associated with sarcoma. PMID: 27498913
- The carriage of homozygous minor allele of DNA repair gene XPD Gln751Gln is a risk factor for thyroid cancer in persons from Ukrainian population exposed to ionizing radiation and is associated with the increased levels of chromosomal instability. PMID: 28230823
- In conclusion, we provide a useful resource on the mutational landscape of ERCC2 mutations in hereditary BC/OC patients and, as our key finding, we demonstrate the complexity of correct interpretation for the discovery of "bonafide" breast cancer susceptibility genes PMID: 27504877
- Accumulating evidence suggests that XPA and the helicase activity of transcription factor IIH (TFIIH) cooperate to verify abnormalities in damaged DNA chemistry. (Review) PMID: 27264556
- The data indicate that XPD, as a part of the TFIIH complex, due to its iron-sulfur center interacts with the iron sulfur cluster assembly proteins and may interact with other proteins in the cell to mediate a diverse set of biological functions including cell cycle regulation, mitosis, and mitochondrial function. (Review) PMID: 27262611
- genetic association studies in population of women in Poland: Data suggest that an SNP in ERCC2 (C to A, R156R, rs238406) is associated with ovarian carcinoma; this SNP is also associated with ovarian cancer progression, assessed by the degree of histological grades and FIGO staging. PMID: 27888704
- The analysis results showed that the following polymorphisms were correlated with susceptibility to lung cancer: rs4646903 in CYP1A1 (P < 0.001), rs1048943 in CYP1A1 (P < 0.001), rs1695 in GSTP1 (P < 0.05), rs13181 in ERCC2 (P < 0.001), and rs25487 in XRCC1 (P < 0.05); no such correlation existed in rs861539 in XRCC3 (P > 0.05). PMID: 27819744
- There was no association between the XPD Lys751Gln polymorphism and CRC risk. PMID: 27686263
- Polymorphisms in XPD gene is associated with gastrointestinal stromal tumours. PMID: 27460091
- No association was found between ERCC2 rs13181, and ERCC2 rs1799793 and overall survival of gastric cancer. PMID: 27173253
- Study provides evidence that genetic polymorphisms in XPD-751, XRCC1-194 and XRCC1-399 were all correlated with non-small cell lung cancer occurrence. PMID: 25308691
- the ERCC2 rs13181 polymorphism is correlated with an increased risk of gliomas in codominant and recessive models, which suggests that this polymorphism could influence the etiology of gliomas. PMID: 27323065
- XPD gene polymorphism is associated with acute myeloid leukemia. PMID: 26779634
- we conclude that ERCC2 gene polymorphism R156R may be associated with an increased risk of endometrial cancer. PMID: 26349749
- No significant association was found for XPD Asp312Asn polymorphism with the risk of autism spectrum disorder. PMID: 27064873
- Frequency of XPD-Gln in IFH suggests that this variant may protect against OSCC. PMID: 26742000
- Data did not find any association between ERCC2 or ERCC3 gene polymorphisms and the development of osteosarcoma. PMID: 27051024
- Photosensitive form of trichothiodystrophy associated with a novel mutation in the XPD gene. PMID: 26577220
- No significant association was found between the ERCC2 rs13181 polymorphism and the risk of pancreatic cancer in the codominant, dominant, and recessive models. PMID: 27051038
- XPD Lys751Gln polymorphism may be a risk factor for CCRCC. Regarding the XRCC3 Thr241Met polymorphism, an association with CCRCC was found only in XRCC3 Thr241Met/XPD Lys751Gln combined genotypes. PMID: 26682510
- Results found no significant association between ERCC2 rs13181 polymorphism and breast cancer in Chinese population. PMID: 26985954
- Polymorphisms of ERCC2 gene are associated with HPV-positive cervical cancer. PMID: 25812040
- Our data suggest that deregulation of ERCC2 in head and neck cancer (HNC) has the potential to predict a more aggressive cancer phenotype and may be considered a possible biomarker for improved diagnosis and prognosis of HNC. PMID: 26659720
- The aim of this study was to investigate the association between polymorphisms of XRCC1 Arg399Gln, XRCC3 Thr241Met, and XPD Lys751Gln and laryngeal cancer risk. PMID: 26898429
- ERCC1 rs11615 and rs3212986 and ERCC2 rs13181 and rs1799793 polymorphisms were genotyped using the polymerase chain reaction restriction fragment length polymorphism PMID: 26823845
顯示更多
收起更多
-
相關疾病:Xeroderma pigmentosum complementation group D (XP-D); Trichothiodystrophy 1, photosensitive (TTD1); Cerebro-oculo-facio-skeletal syndrome 2 (COFS2)
-
亞細胞定位:Nucleus. Cytoplasm, cytoskeleton, spindle.
-
蛋白家族:Helicase family, RAD3/XPD subfamily
-
數據庫鏈接:
Most popular with customers
-
-
YWHAB Recombinant Monoclonal Antibody
Applications: ELISA, WB, IHC, IF, FC
Species Reactivity: Human, Mouse, Rat
-
Phospho-YAP1 (S127) Recombinant Monoclonal Antibody
Applications: ELISA, WB, IHC
Species Reactivity: Human
-
-
-
-
-